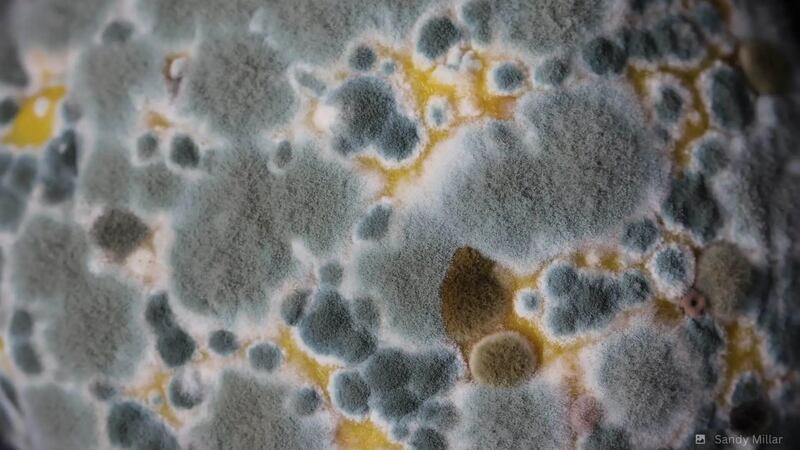
Hongos

Todo surgió a raíz de un video viral en TikTok, en el que una mujer en Estados Unidos mostraba como Vans destruyó decenas de zapatillas frente a una de sus tiendas.
“¿No solo tiran zapatillas nuevas, sino que las cortan para que las personas necesitadas no puedan usarlos? Vans, no volveré a tu tienda por lo pronto”, afirmó Sophia Schiaroli en su cuenta de videos cortos.
Sin embargo, la empresa tenía una muy buena razón para hacer lo que hizo. Una muy, muy asquerosa.
Luego que el video se viralizara, superando las 2.4 millones de vistas, los 385 mil me gusta y los 22 mil comentarios, un portavoz de Vans explicó cuál fue el motivo de la tienda en Philadelphia para destruir sus zapatillas.
Según reseñó Complex Sneakers, la razón por la que Vans destruyó los calzados deportivos es que… tenían moho. Les había crecido hongos.
“Se consideró que no era seguro donar los productos debido al crecimiento orgánico causado por factores externos y ambientales”, dijo un portavoz de Vans en un comunicado entregado a Complex Sneakers.
¿Cómo apareció moho en las zapatillas de Vans?
El moho es un organismo microscópico que vive en la materia animal o vegetal, ayudando en la descomposición de la materia muerta.
Crece y se multiplica cuando existe algo de humedad concentrada que se mezcla con materia orgánica.
Así que, lo más probable, es que las zapatillas de la tienda de Philadelphia se hayan humedecido durante mucho tiempo, haciendo que aparecieran los hongos.
Evidentemente, lo hecho por Vans era lo más adecuado. ¿Imaginan qué hubiera sucedido si regalaban zapatillas con moho?
En todo caso, la compañía de zapatillas explicó: “Vans siempre dará prioridad a la donación de productos utilizables a aquellos que lo necesitan. Después de investigar la situación en nuestra ubicación de Walnut St., hemos confirmado que se consideró que no era seguro donar estos productos”.
“Dicho esto, estamos revisando activamente nuestros protocolos minoristas para garantizar que los productos se reciclen adecuadamente”, cerró la empresa norteamericana.
